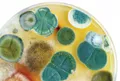
Dangerous Consequences of Mold

Helping homeowners create safer, healthier living environments
Understanding Household Mold
Mold: it's as old as the Earth and it's everywhere - inside homes and out. Under the right conditions, it can start to grow inside your house.
While household mold isn't a new issue, it's important to understand what mold is, how it grows in your home, and what you can do about it.
Our resources help you learn about routine maintenance to prevent mold problems and effective methods for removing existing mold in your home.
Why Mold Prevention Matters
Preventing mold is crucial for maintaining a healthy home environment. Mold can cause structural damage to your property and lead to various health issues, especially for those with allergies, asthma, or compromised immune systems.
By understanding how mold grows and implementing proper prevention techniques, you can protect both your home and your family's health. Regular inspections, controlling moisture, and proper ventilation are key strategies in keeping your home mold-free.
Browse our comprehensive resources to learn everything you need to know about identifying, preventing, and addressing mold issues in your home.
Explore Our Resources

How to Clean Mold Off Walls
Learn how to clean mold off walls safely and effectively with our complete step-by-step guide.
What is Mold?
Learn about what mold is, its characteristics, and how it affects our environment.
How Does Mold Grow?
Understand the conditions that allow mold to thrive and spread in your home.
How to Prevent Mold
Effective strategies to prevent mold from growing in your home.
Dangerous Consequences of Mold
Learn about the health risks and property damage associated with mold infestations.

Common Types of Dangerous Mold
Discover the 4 most common types of mold that can be harmful to human health.

Dealing with Mold Smell
What causes mold odors and how to effectively address them in your home.
HVAC Mold Prevention
How to keep your HVAC system free from mold and maintain healthy air quality.

Mold When House Hunting
How to look for signs of mold when shopping for a new home.
Mold and Wheezing
How mold exposure can cause respiratory issues like wheezing and breathing difficulties.
Mold Impact on Roofs
Six ways mold can damage your roof and what to do about it.
Mold FAQ
Frequently asked questions about mold prevention, detection, and removal.